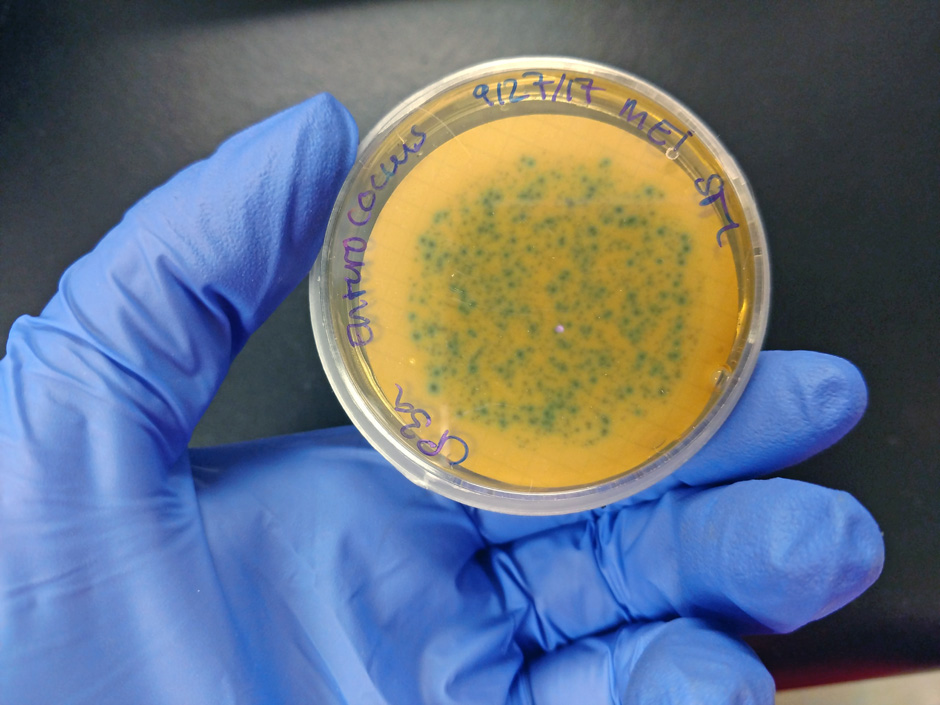
bacteria beach

Fecal Bacteria Rises with Sea Level on Texas Beaches
Nicole Powers holds a petri dish with enterococcus bacteria collected from Corpus Christi Bay. (Credit: Nicole Powers)
Nicole Powers holds a petri dish with enterococcus bacteria collected from Corpus Christi Bay. (Credit: Nicole Powers)As climate change lifts the sea level in the Gulf of Mexico, it’s lifting levels of enterococci bacteria on Texas’s beaches, too.
New research out of the Gulf shows that high levels of enterococci bacteria, which come from humans and other animals and can cause disease, are correlated with proximity to large human populations and sea level rise and are increasing over time.
The research highlights an area of growing concern for public health and safety on popular recreational beaches. While sea level is projected to continue rising, it’s not a guarantee that bacteria levels will as well.
“Bacterial pollution could be expected to increase as time goes on and as the coastal population is increasing and as sea levels continue to rise,” said Nicole Powers, the lead author of the study and a recent doctoral graduate from Texas A&M—Corpus Christi.
The sea level rise and population growth affecting the beaches in Texas affects coastal communities around the world; the bacteria problem on the Gulf is also a problem elsewhere. Share on X
A beach visitor at a Houston beach. Beaches in Texas near large cities had higher levels of fecal bacteria. (Credit: Pixabay/F. Muhammad)
Bacteria Rises with Sea Level, Population, and Time
A team of researchers from Texas A&M—Corpus Christi and the Texas General Land Office analyzed beach water quality data from 2009-2020. Their analysis was recently published in Marine Pollution Bulletin.
“We set out to look at recent spikes in the bacteria levels in certain regions along the Texas Coast, but we had data that spans back over ten years,” Powers said. The focus shifted to long-term trends.
The longer look revealed a significant problem.
Of the 66 beaches the team analyzed, 22 regularly exceeded the U.S. EPA action level for beaches. (The EPA recommends that beach samples not exceed a geometric mean of 35 colony-forming units of enterococci per 100 milliliters and that samples not exceed 130 colony forming units per 100 milliliters over in more than 10% of samples.)
All but one of the beaches exceeded this recommendation multiple times and 19 beaches broke the scale—they exceeded the upper limit of detection. Harris County, which includes Houston, and Matagorda County exceeded the U.S. EPA limits more than 20% of the time.
Over time, enterococci levels have been increasing in coastal Texas. It was one of three correlations, along with rising sea levels and population that the analysis revealed.
The Problem with Enterococci
Enterococci serve as a proxy for other fecal bacteria that could harm beachgoers.
“In US surface waters, outdoor recreational activities such as swimming, boating, and fishing account for approximately 4 billion recreational events annually. These recreational events result in 90 million gastrointestinal, respiratory, ear, eye, or skin-related illness,” the study reports. These illnesses cost $2.2-3.7 billion.
Bacteria is the leading cause of surface water problems in Texas. A 2019 report by the Environment America Research and Policy Center and Frontier Group found that over half of America’s beaches exceeded bacteria standards at least once in the previous year.
The beaches examined in this study are regularly used for recreation. The data used in the study came from the Texas Beach Watch program, which monitors water quality data at recreational beaches along the Gulf Coast.

Enterococcus bacteria. (Credit: Public Domain/Wikimedia)
Possible causes for rising bacteria levels
The study found correlation but didn’t look at specific causes. Some potential explanations have been found elsewhere.
Rising sea levels can compromise septic systems, which can then leak sewage into the environment.
“It isn’t necessarily the number of septic systems in coastal areas that are causing high bacteria levels,” Powers said. “I’m not saying that it’s bad to have septic systems, by any means—it could have to do with the age and maintenance of those systems, as well as the condition of underground sanitary sewer systems too.”
Research in North Carolina showed septic and sewer systems being harmed by rising sea level and increased rainfall. Others made similar findings in Rhode Island and in Florida.
The relationship between cities and enterococci pollution makes sense, too, since more people will produce more of the bacteria.
The team also found a difference between beaches along bays and beaches along the Gulf coast. Gulf coast beaches, which are flushed by waves more than the calmer, more protected bayside beaches, had lower levels of enterococci. Bayside beaches had higher levels of enterococci and were often closer to large cities, as well.
“Sea level rise and population growth are not limited to the Gulf coast,” the authors write. Many coastal communities face similar challenges.
The Environment America Research and Policy Center and Frontier Group report showed that 85% of Gulf Coast beaches exceeded bacteria recommendations for at least one day in 2018. But, 67% of West Coast beaches examined did as well. The East Coast, which had the best numbers of any region included, had 48% of beaches exceed the recommendation on at least one day. (The Great Lakes, which face different challenges than marine coastal regions, had 68% of beaches over the limit at least one day.)
The infrastructure problems that contribute to this issue of bacterial pollution can be remedied.
One way authorities can begin tackling this problem, according to the study’s authors, is by “focusing on the maintenance and repair of coastal infrastructure that is susceptible to damage from urbanization and rising sea levels.”
“This isn’t just a doomsday event. There are things we can do to help and make this problem better,” Powers said.











0 comments